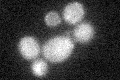
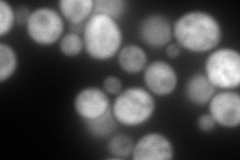
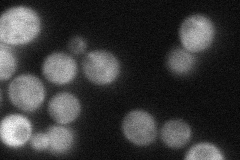
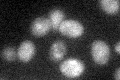

View description
2-enoyl thioester reductase, member of the medium chain dehydrogenase/reductase family; localized to in mitochondria, where it has a probable role in fatty acid synthesis
Localization:
Intensity:
Fold change:
Significance:
-
C’ GFP library in SD
mitochondria18.18 -
N' NOP1pr-GFP in SD

cytosol270.734 -
N' TEF2pr-mCherry in SD
cytosol330.564 -
N' NATIVEpr-GFP in SD
cytosol58.241 -
N' TEF2pr-VC and Cyto-VN in SD

#N/A0 -
C’ GFP library in SD+DTT

mitochondria18.841.03No -
C’ GFP library in SD+H2O2

mitochondria19.671.08No -
C’ GFP library in Starvation Media
mitochondria39.042.14No -
C’ GFP library on the background of Pup2-DaMP

mitochondria -
C’ GFP library on the background of CCT mutant

mitochondria18.7941.03357No
